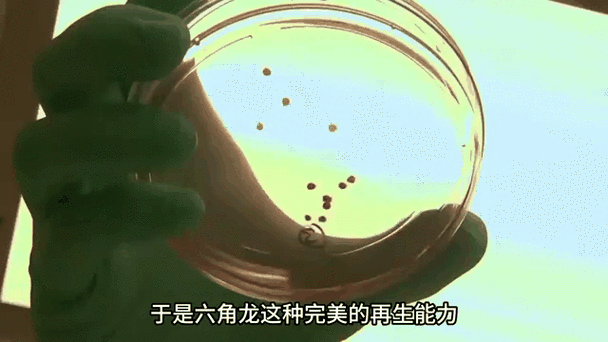
40公分紅龍魚喂食方法：40公分紅龍魚喂食頻率調整，紅龍魚喂食頻率調整方法

40公分紅龍魚喂食方法:40公分紅龍魚喂食頻率調整,紅龍魚喂食頻率調整方法
以下是六角龍魚小魚苗的飼養要點:
一、環境控制
- 魚缸選擇:幼體建議使用30厘米以上魚缸,水位保持15-30厘米,需放置陰涼處避免陽光直射1。
- 水質管理:使用晾曬24小時或除氯處理過的水,每周換水1/3-1/2,新水與舊水溫差不超過3℃,pH值維持在7.0-8.51。
- 水溫調節:最佳水溫15-20℃,夏季需用冷水機或冰袋降溫,冬季不低于10℃1。
 01:3300:00/01:331.六角龍魚的養護環境2.水溫和水質的控制3.喂食方法
01:3300:00/01:331.六角龍魚的養護環境2.水溫和水質的控制3.喂食方法二、喂食方法
- 餌料選擇:優先投喂活體豐年蝦、小魚小蝦(需消毒),或凍干紅蟲、專用下沉飼料23。
- 喂食頻率:幼體每日2次,成體每周4-5次,每次投喂量控制在5分鐘內吃完1。
- 輔助工具:可用鑷子夾住活餌在魚苗眼前晃動,刺激其捕食本能3。
 01:30分享六角恐龍飼養經驗,先從怎么投喂開始,一起養起來吧養魚的大潘
01:30分享六角恐龍飼養經驗,先從怎么投喂開始,一起養起來吧養魚的大潘 02:10小六角恐龍魚飼養常見問題與注意事項金股俠E369
02:10小六角恐龍魚飼養常見問題與注意事項金股俠E369三、健康監測
- 常見病癥:
- 霉菌感染:體表出現白毛,需用真菌藥粉或鹽水藥浴45。
- 腸胃炎:表現為拒食、腹脹,可喂含慶大霉素的飼料5。
- 日常觀察:鰓毛應舒展,活動需活躍;若發現浮頭、體色異常需立即隔離檢查14。

四、注意事項
- 避免混養:同類可能咬尾,其他魚類會攻擊鰓毛1。
- 底材選擇:禁用沉木,建議光滑石塊或底沙,防止誤食14。
- 過濾系統:使用低水流過濾器或每日換水,避免魚苗被吸入1。
通過以上管理,可顯著提高魚苗存活率。若需進一步優化,可參考專業飼養視頻36。
新手怎么養六角龍魚卡覓智庫_視界養寵知識分享:六角龍魚怎么養小寵文文分享六角恐龍飼養經驗,先從怎么投喂開始,一起養起來吧養魚的大潘小六角恐龍魚飼養常見問題與注意事項金股俠E369六角恐龍魚常見病囍囍孵化六角恐龍魚第9天,將近300顆魚卵,都變成了會動的小魚苗嗶哩嗶哩編輯六角龍魚小魚苗多久喂一次
如何判斷六角龍魚是否健康
六角龍魚小魚苗多久能長大
推薦閱讀:
文章版權聲明:本站文章來之全網,如有雷同請聯系站長微信xlyc002 ,轉載或復制請以超鏈接形式并注明出處。

發表評論